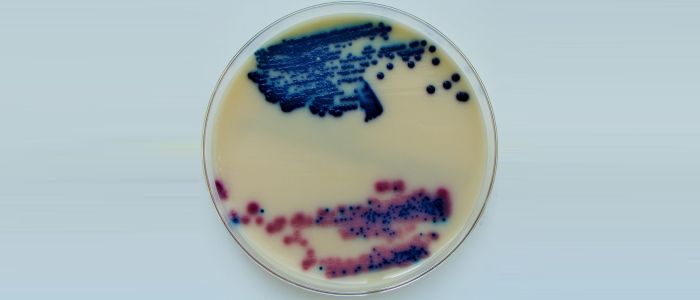
У нас новий антибіотик, і ми можемо створити його в лабораторії
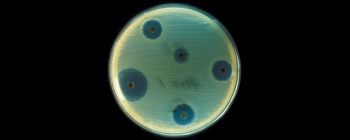
Застарілий антибіотик може знайти нове застосування проти супербактерій

У нас новий антибіотик, і ми можемо створити його в лабораторії
ПЕРСПЕКТИВНА ВІДКРИТТЯ. Бактерії - це рухливі дрібниці. Ми ізолюємо антибіотики, щоб убити їх, і вони розвиваються, щоб ухилитися від атаки. Це називається антибіотикорезистентністю, і це стало настільки погано, що Організація Об'єднаних Націй (ООН) фактично оголосила її криза ще у вересні 2016 року.
Тепер команда китайських дослідників вважає, що вони знайшли нову зброю проти стійкості до антибіотиків: грибкове з'єднання, зване албоміціном δ2, яке ми дійсно можемо відтворити в лабораторії.
Вони опублікували своє дослідження у вівторок в журналі Nature Communications.
КРАЩЕ, НІЖ пеніциліну. З попередніх досліджень ми знали, що альбоміціни володіють антимікробними властивостями, але тільки після того, як ця дослідницька група викопала грибкові з'єднання, вони дізналися, що одне специфічне з'єднання, альбоміцін δ2, було особливо корисно при вбивстві бактерій. Він навіть перевершив ряд встановлених антибіотиків, включаючи пеніцилін, при випробуванні проти відомого важкого лікування метицилін-резистентного Staphylococcus aureus (MRSA).
Більшість антибіотиків, які ми використовуємо сьогодні, є природними речовинами, і вони часто мають складні хімічні структури. Це означає, що більшу частину часу їх дуже важко відтворити в лабораторії, а це означає, що вони займають більше часу, щоб розвиватися у великих кількостях. Однак дослідники з'ясували, як ми могли б синтезувати альбоміцін δ2, що дає нам можливість оцінювати його набагато ширше, ніж якби ми покладалися на зразки, отримані природним шляхом.
НЕ ШВИДКО ДОСИТЬ. Незважаючи на те, що ООН визнала резистентність до антибіотиків як криза, ми просто не розробляємо нові антибіотичні препарати так швидко, як бактерії розвивають здатність чинити опір їм. Якщо ми продовжимо шлях цим шляхом, ми зіткнемося з майбутнім, в якому інфекція, яка колись була легко лікувати, могла бути небезпечною для життя.
Але якщо ми зможемо об'єднати розробку нових антибіотиків з більш профілактичним обслуговуванням і меншим надмірною приписом існуючих ліків? У нас, по крайней мере, є шанс випередити проблему. Albomycin δ2 може бути важливим інструментом, оскільки ми переходимо в більш стійке до антибіотиків майбутнє.
Джерела: Nature